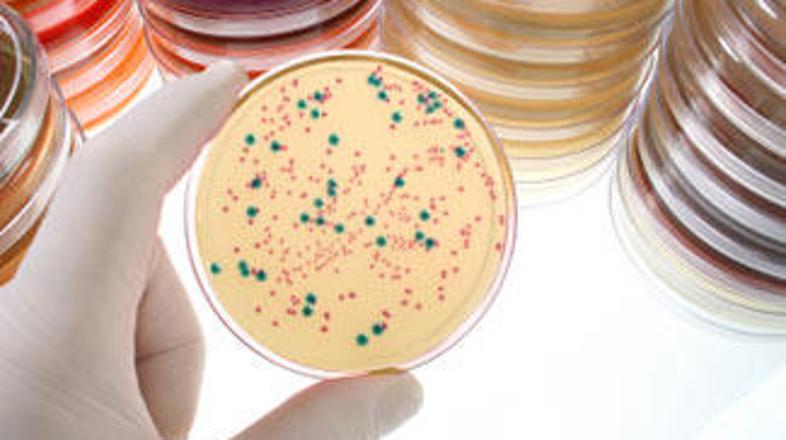
"Mišji samci, ki smo jih okužili z bakterijo, so pokazali okrepljene duševne, fi

Znanstveniki so bakterijo v šali poimenovali
"starodavna viagra", testirali pa so jo že na miših, katerih proučevanje bi moralo dati
odgovore na vprašanja o duševnih sposobnostih, fizični moči in seksualni aktivnosti.
Obuditev od mrtvih?
Ti rezultati so nepričakovani stranski proizvod natančnih proučevanj izumrlih živali, katerih
dobro ohranjeni ostanki so bili najdeni v večnem ledu v pokrajini Jakutiji, ki se nahaja v vzhodni
Rusiji. Ruski znanstveniki ob pomoči japonskih in ameriških znanstvenikov preučujejo DNK, da bi
tako lahko poskusili klonirati mamuta in dlakastega nosoroga ter jih tako obudili od mrtvih.
Po koncu ekspedicije je profesor
Anatolij Bruškov s Tjumenske univerze povedal:
"Našli smo nekaj, kar bi lahko bila zelo stara vrsta bakterije, ki še vedno živi v pesku
ledenega področja. Nikjer na svetu še ne obstajajo dokazi o obstoju te vrste bakterije. To je
edinstveno doživetje, saj še noben znanstvenik do sedaj ni uspel dokazati obstoja bakterije za
dolgo življenje."
Čeprav se je bakterija nahajala na področju, ki je polno okostij mamutov in dlakastih
nosorogov, znanstveniki menijo, da med njimi in bakterijo ne obstaja povezava. Mamuti so se namreč
razvili iz azijskih slonov pred 4,8 milijona leti, izumrli pa so pred približno deset tisoč leti,
medtem ko so sledi endemske pritilikave vrste, stare dva tisoč let, našli v Kaliforniji. Ruski
znanstveniki trdijo, da je bakterija stara od tri do pet milijonov let, čeprav bomo morali na prve
rezultate laboratorijskih eksperimentov še počakati, poroča spletni portal index.hr.
Okrepljene mentalne, fizične in seksualne sposobnosti
"Napravili smo niz testov. Rezultati kažejo, da enostavni organizmi, kot so vinske mušice,
živijo zelo dolgo," je povedala znanstvenica
Vera Samsonova.
"Mišji samci, ki smo jih okužili z bakterijo, so pokazali okrepljene duševne, fizične in
seksualne sposobnosti, medtem ko so samice imele mladiče pri starosti, ki bi
bila
pri človeku enakovredna 70. letu življenja," je še dodala Samsonova.
"Ne moremo obljubiti, da bomo, ali smo, našli zdravilo za nesmrtnost oziroma dolgo življenje.
Realno gledano smo odkrili, da te vrste bakterija živi zelo dolgo ter da bo zagotovo imela učinek
na počasnejše staranje. Če bi življenje lahko podaljšali samo za deset let, bi bilo to veličastno
odkritje," je povedal Bruškov.
Znanstveniki odkrili starodavno viagro
Ruski znanstveniki, ki delajo na grobišču mamutov v Sibiriji, trdijo, da so našli bakterijo, ki lahko izboljša seksualne sposobnosti ter celo podaljša človekovo življenje.




